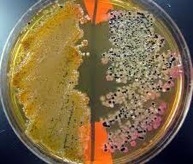

Prof. Jeremy Semrau’s Research Site



It is my general research goal to enhance our understanding of in situ microbial diversity and activity by developing new biochemical and molecular techniques to better monitor in situ microbial communities. With more accurate information generated from these tools, bioremediation strategies can be enhanced by helping us identify what parameters affect the viability and success of in situ bioremediation. This work is inherently interdisciplinary and I interact to a great degree with my colleagues in hydraulics, geostatistics, aquatic chemistry, and surface chemistry to develop new solutions to persistent problems.
Research Statement

http://microbes.nres.uiuc.edu/NRES512.htm
